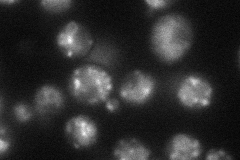
YDR319C
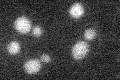
YDR319C

View description
Putative protein of unknown function, identified as an ortholog of the highly conserved FIT family of proteins involved in triglyceride droplet biosynthesis; interacts with Sst2p and Hsp82p in high-throughput two-hybrid screens
Localization:
Intensity:
Fold change:
Significance:
-
C’ GFP library in SD

below threshold17.64 -
N' NOP1pr-GFP in SD
punctate44.2401 -
N' TEF2pr-mCherry in SD

vacuole83.654 -
N' NATIVEpr-GFP in SD

below threshold23.8513 -
N' TEF2pr-VC and Cyto-VN in SD

below threshold24.941 -
C’ GFP library in SD+DTT

cytosol30.931.75No -
C’ GFP library in SD+H2O2

cytosol22.851.29No -
C’ GFP library in Starvation Media
cytosol24.521.38No -
C’ GFP library on the background of Pup2-DaMP

N/A -
C’ GFP library on the background of CCT mutant

N/A0N/AYes
